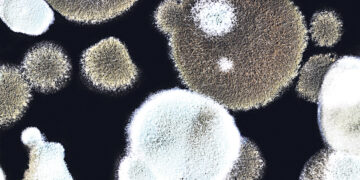
ВОЗ предупреждает  о новых грибковых заболеваниях

Но пока этим грибковым заболеваниям уделялось слишком мало внимания. Надзор и сбор сведений следует, по мнению учёных, значительно улучшать. Однако одной лишь статистикой нельзя ограничиваться.
ВОЗ разделила 19 грибковых патогенов на три группы. В первую группу входят четыре наиболее опасных патогена, которые, по мнению учёных, срочно нуждаются в более тщательном исследовании: Cryptococcus neoformans, который может вызывать менингит, Candida auris, который может поражать центральную нервную систему, органы, кости и глаза; Aspergillus fumigatus, который может попадать в лёгкие, и Candida albican, поражающий слизистые оболочки рта, горла, половых органов и кишечника. Последний редко вызывает какие-либо проблемы у здоровых людей, но, тем не менее, может быть опасен для жизни людей с ослабленным иммунитетом.
Особенно опасен грибковый возбудитель Candida auris, который в основном поражает пациентов в клиниках и устойчив ко многим действующим веществам. Сначала заболевания от Candida auris фиксировались лишь в Японии, но с 2009 года они распространились более чем в 50 странах.
Грибковые заболевания быстро распространяются, не только из-за глобального потепления, но и из-за международной торговли и мобильности людей по всему миру. Кроме того, у патогенов всё чаще развивается устойчивость к известным активным ингредиентам.
«Для большинства грибковых патогенов не существует быстрой и чувствительной диагностики, а те диагностики, которые признаны во всём мире, не являются ни широко известными, ни доступными по цене», – заявили в ВОЗ. Прежде всего, люди с перенесёнными тяжёлыми заболеваниями или с ослабленной иммунной системой могут легко заболеть грибковыми инфекциями, которые часто поздно распознаются и всё чаще не поддаются лечению существующими лекарствами. «Диагностика и лечение грибковых заболеваний остаются далеко позади бактериальных заболеваний», – заявил доктор Нил Стоун (Neil Stone), консультант по инфекционным заболеваниям и микробиологии в больницах Университетского колледжа Лондона.
ВОЗ призывает правительства и научные учреждения расширять лабораторные возможности для диагностики и мониторинга, больше инвестировать в исследования и разработки и шире проводить обучение медицинского персонала, чтобы по возможности предотвратить грибковые инфекции с самого начала.
Виктор Фишман